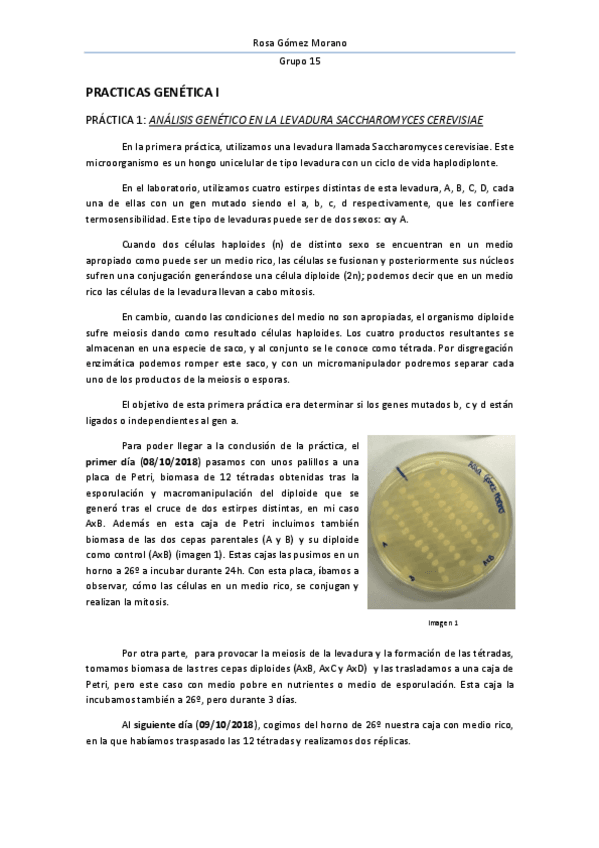
Miniatura del documento INFORME-PRACTICAS-LABORATORIO.pdf

INFORME-PRACTICAS-LABORATORIO.pdf

Portada

Asignatura
account_balance
Grado en Biología (US)
Fecha de subida
02 nov 2019
Categoría
practicas
Etiquetas
content_copy

Portada
Asignatura
Grado en Biología (US)
Fecha de subida
02 nov 2019
Categoría
practicas
Etiquetas